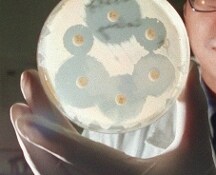

Di problematiche psicologiche si può soffrire sin da piccoli

Sono pochi e per la maggior parte privati i Centri che in Italia si prendono cura di chi sia affetto dalla malattia di Alzheimer o da altre forme di demenza

Una condizione comune a più di mezzo milione di italiani. Che dimenticano progressivamente ogni cosa della propria vita, fino a non riconoscere più neppure i figli, se stessi. Ma se stimolati con tecniche opportune, e seguiti da specialisti, è possibile rallentare molto la progressione della...

Ogni anno a. metà marzo, la settimana dedicata al cervello

Marzo è il mese della prevenzione

I temi di questo appuntamento con bastalasalute sono la settimana mondiale del cervello, come intercettare precocemente il decadimento delle funzioni o l’insorgere di malattie; il punto sul Servizio Sanitario Nazionale, tra autonomia differenziata delle Regioni, finanziamenti, mancanza di personale....
Nel 2050 le infezioni batteriche costituiranno la principale causa di decessi


In questa puntata di Bastalasalute Gerardo D’Amico si occupa del “progetto smile”, lo studio dell’Istituto Nazionale dei Tumori di Milano che parte il prossimo Aprile che aiuterà i forti fumatori ad abbandonare la sigaretta grazie ad un farmaco galenico a base di cisteina. E poi, il cancro alla...

A Londra si sarebbe negativizzato un malato di HIV dopo essersi sottoposto al trapianto di midollo perchè affetto anche da un tumore del sangue: la sua fortuna è stata che il donatore era una delle poche persone al mondo con una mutazione genetica che lo rende resistente al virus. Gerardo D'Amico ha...

Si potranno eseguire trattamenti personalizzati, adeguando le terapie mediche e chirurgiche in base al rischio effettivo della singola paziente di sviluppare metastasi nel tempo.

Per fare un concorso nelle Forze dell'Ordine, nei Vigili del Fuoco, o per partecipare ad un programma Erasmus occorrerà essere a posto coi vaccini: questa l'intesa che sarebbe stata raggiunta tra ministeri. Intanto sta per scadere il termine per regolarizzarsi con le vaccinazioni, entro l'11 marzo...